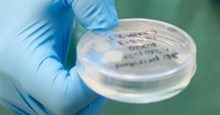
Chuyện khó ngờ: Tạo thành công mô sụn làm từ tế bào gốc qua thiết bị in 3D

Một nghiên cứu mới thấy phụ nữ sau mãn kinh có nguy cơ gãy xương cao nhất có thể được khắc phục từ liệu pháp hoóc môn.
Cụ thể, các nhà nghiên cứu tại Đại học Buffalo vừa phát hiện ra rằng phụ nữ có nguy cơ di truyền cao nhất liên quan tới việc gãy xương có thể sữa chửa bằng liệu pháp hoóc môn.
Trước giờ, mật độ xương (MBD) ở phụ nữ bắt đầu giảm khi tuổi cao hơn, dễ gãy xương hơn. Tuy nhiên, không riêng gì tuổi tác mà yếu tố di truyền cũng có liên quan tới việc tăng nguy cơ gãy xương.

Nghiên cứu khoảng 10.000 phụ nữ từ Chương trình Nghiên cứu về Sức khoẻ Phụ nữ Quốc gia, một nghiên cứu dài hạn của WHI đã khảo sát, áp dụng các liệu pháp hoóc môn cũng như gen trên những phụ nữ da trắng sau mãn kinh thường hay bị gãy xương.
Để có được nghiên cứu này, nhóm các nhà khoa học đã sử dụng một tập hợp các gen liên quan tới nguy cơ gãy xương qua các phương pháp phân tích meta về bộ gen đặc thù.
Heather Ochs-Balcom, một giáo sư về dịch tễ học và sức khoẻ môi trường tại Trường Y tế Công cộng và Y tế của UB cho biết: "Chúng tôi phát hiện ra rằng những phụ nữ có nguy cơ cao bị gãy xương do di truyền có thể được bảo vệ, phục hồi chữa trị từ các liệu pháp hoóc môn– Ông nói trong một thông cáo báo chí".

Nghiên cứu này giúp hiểu rõ hơn từ những lợi ích tối ưu mà liệu pháp hoóc môn mang lại cho sức khỏe xương. Đây là một phát hiện quan trọng cho phụ nữ cũng như các y bác sĩ đã và đang sử dụng liệu pháp hoóc môn để điều trị một số loại bệnh.
Trong phát hiện này, nhóm nghiên cứu cũng đã phát hiện ra hai điểm rủi ro di truyền gây bệnh gãy xương dựa trên 16 biến thể gen có liên quan tới gãy xương và 50 biến thể khác liên quan tới mật độ xương từ đó họ đánh giá hiệu quả, sức ảnh hưởng của liệu pháp hoóc môn với các chứng gãy xương do di truyền gây ra.
Ochs-Balcom cho biết: "Nghiên cứu của chúng tôi thể hiện một cái nhìn đầu tiên về cách mà các khuynh hướng chữa trị mới đã được phá vỡ ở một tầm cao mới, liên quan đến việc sử dụng liệu pháp hoóc môn trong điều trị. Điều này rất quan trọng bởi vì như những nghiên cứu trước đây mà WHI đã xác định có những nguy cơ gây bệnh và lợi ích có liên quan hiệu quả với liệu pháp hoóc môn có giá trị y học tương quan. Đây có thể là loại thuốc chữa trị mới, hiệu quả, ít gây hại, ít tác dụng phụ nhất”.
Các nhà nghiên cứu nhận thấy rằng phụ nữ có thể dùng liệu pháp hoóc môn làm giảm nguy cơ gãy xương, đặc biệt là với phụ nữ có mật độ khoáng trong xương thấp. Nghiên cứu này vừa được công bố trên tạp chí Journal of Clinical Endocrinology and Metabolism.
Hướng dẫn AI
Học IT

Hàm Excel